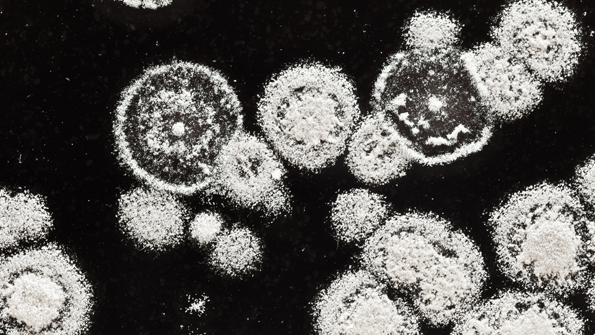
Mold Web

Mold Hazards, Wrongful Termination Lead to Settlement against IFCO Services
A whistleblower at an IFCO Services plant in Pennsylvania alerted OSHA about mold and electric hazards, leading the regulatory body to issue a $105,000 settlement after the company retaliated against the worker.
From Apr. 8 to June 13, 2014, the employee repeatedly informed IFCO, a pallet services company, about suspected mold growing behind filing cabinets in an office at the plant. For more than two months, the company took no action to correct the unhealthy working condition, despite admitting there was mold present. Instead, IFCO fired the woman less than three weeks after she complained again about her health concerns.
"IFCO showed a total disregard for the well-being of its employees, who physically suffered due to ongoing exposure to mold hazards," said Oscar L. Hampton, regional solicitor in Philadelphia in a statement.
The employee filed a complaint with OSHA alleging her termination by IFCO was retaliation for reporting the mold hazard. The agency found that the company violated the anti-discrimination provision of the Occupational Safety and Health Act, or Section 11(c), when it terminated the complainant because she had engaged in protected activities under the Act.
"IFCO's refusal to take immediate action to eliminate what was confirmed to be a serious mold hazard left its employees at risk of developing a chronic health condition," said Richard Mendelson, OSHA regional administrator in Philadelphia. "They also retaliated against the employee who alerted the company and OSHA to the hazard. No worker should have to fear retaliation when they identify a workplace safety and health concern."
OSHA found that IFCO failed to reinstate the employee, as well as compensate her for lost wages and other damages suffered as a result of the improper termination.
In addition to the monetary settlement, the judgment requires that IFCO expunge the termination and any related disciplinary action from the complainant's file, as well as post notices at its work site for 60 days stating that it will not discriminate or retaliate against employees involved in activities protected by Section 11 (c) of the Act.
The company must also provide OSHA handouts entitled "Filing Whistleblower Complaints under Section 11(c) of the OSHA Act of 1970" to each employee at the worksite, in English and/or Spanish as appropriate. The company is also permanently enjoined from future 11 (c) violations.